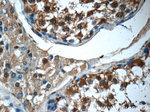
14-3-3 Antibody in Immunohistochemistry (Paraffin) (IHC (P))

Search
Proteintech
14-3-3 Polyclonal Antibody
{{$productOrderCtrl.translations['antibody.pdp.commerceCard.promotion.promotions']}}
{{$productOrderCtrl.translations['antibody.pdp.commerceCard.promotion.viewpromo']}}
{{$productOrderCtrl.translations['antibody.pdp.commerceCard.promotion.promocode']}}: {{promo.promoCode}} {{promo.promoTitle}} {{promo.promoDescription}}. {{$productOrderCtrl.translations['antibody.pdp.commerceCard.promotion.learnmore']}}
产品信息
14503-1-AP
种属反应
已发表种属
宿主/亚型
分类
类型
抗原
偶联物
形式
浓度
规格
纯化类型
保存液
内含物
保存条件
运输条件
产品详细信息
This antibody was raised against full-length 14-3-3 theta.
Immunogen sequence: MEKTELIQK AKLAEQAERY DDMATCMKAV TEQGAELSNE ERNLLSVAYK NVVGGRRSAW RVISSIEQKT DTSDKKLQLI KDYREKVESE LRSICTTVLE LLDKYLIANA TNPESKVFYL KMKGDYFRYL AEVACGDDRK QTIDNSQGAY QEAFDISKKE MQPTHPIRLG LALNFSVFYY EILNNPELAC TLAKTAFDEA IAELDTLNED SYKDSTLIMQ LLRDNLTLWT SDSAGEECDA AEGAEN (1-245 aa encoded by B C056867)
靶标信息
This gene product belongs to the 14-3-3 family of proteins which mediate signal transduction by binding to phosphoserine-containing proteins. This highly conserved protein family is found in both plants and mammals, and this protein is 99% identical to the mouse and rat orthologs. This gene is upregulated in patients with amyotrophic lateral sclerosis. It contains in its 5' UTR a 6 bp tandem repeat sequence which is polymorphic, however, there is no correlation between the repeat number and the disease.
仅用于科研。不用于诊断过程。未经明确授权不得转售。
生物信息学
蛋白别名: 14-3-3 protein T-cell; 14-3-3 protein tau; 14-3-3 protein theta; 14-3-3 tau; 14-3-3 theta; HS1; OTTHUMP00000165887; Protein HS1; protein tau; protein, theta; tyrosine 3-monooxygenase/tryptophan 5-monooxygenase activation protein, theta polypeptide; unnamed protein product
基因别名: 14-3-3; 14-3-3t; 1C5; 2700028P07Rik; AA409740; AU021156; HS1; R74690; YWHAQ
UniProt ID: (Human) P27348, (Rat) P68255, (Mouse) P68254
Entrez Gene ID: (Human) 10971, (Rat) 25577, (Mouse) 22630